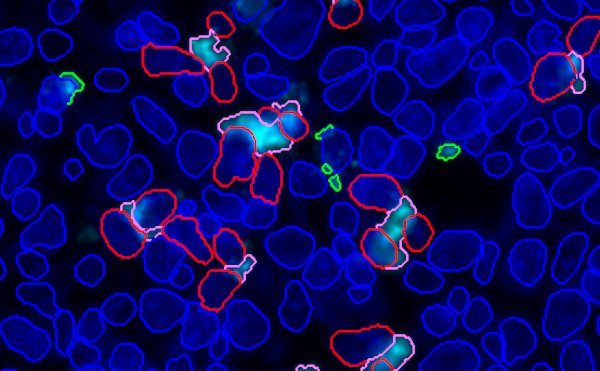

As a spatial biology specialist, Propath’s bioinformatics service enables collaboration at any stage of the data journey.
Whether you’re working with your own data or have generated
these with one of our other services, we’re equipped to deal with
your research needs. From image hosting through to advanced
analysis and statistical support, our expert team can accelerate
discovery through every pixel.


IHC is a complex, multi-parameter staining technique applied across variable fresh frozen and fixed paraffin embedded tissues. As a result, developing an optimum staining protocol is not always straightforward.
Our experience informs our view that high quality IHC with strong signal intensity and low background staining can only be achieved by paying careful attention to the following factors:
New text to go here
The Propath platform for quantitative image analysis and bioinformatics has been designed and validated to be fit-for-purpose for use on clinical trial data. Our controlled environment ensures analyses are conducted according to the principles of informed consent, data integrity, confidentiality and scientific rigour to maintain GCP compliance from sample receipt to data delivery using:
Whether you’re entering our pathway with imported images or generating images with Propath, we seamlessly convert qualitative images into quantitative data for statistical analysis and visualisation. In collaboration with pathologists or subject matter experts, algorithms are trained to extract and quantify features, providing robust and reproducible results.

Our experience across a range of platforms for spatial biology allows us to recommend the most appropriate platform for each research project.
We understand the strengths and limitations of each platform – and how to get the best out of them.

We can analyse a wide range of image types. Our image analysis software is platform agnostic, meaning that we can extract features from histology stains up to 100plex multispectral/imaging mass cytometry images.
We can extract a range of quantitative data, including cell counts, biomarker expression levels, orphological measurements, and spatial relationships between cells. If you can see it, we should be able to measure it.
We offer comprehensive support, including a consultation with our experts, detailed reports, and assistance with data interpretation and visualisation.
The turnaround time depends upon the complexity and volume of the images submitted. Generally, standard analyses are completed within 2-3 weeks, whilst more complex projects may take longer. We will provide an updated estimation upon project initialisation.
Absolutely. We understand that no project is the same and therefore offer bespoke analysis packages tailored to your specific requirements. Our data analysis team is here to discuss your questions and provide advice on how best to ensure the analysis meets your objectives.
Yes, we can assist with the analysis of images from another CRO. Whether you need help with the initial feature extraction or require support in the downstream analysis, our team of experts is here to provide guidance to make the most out of every pixel.